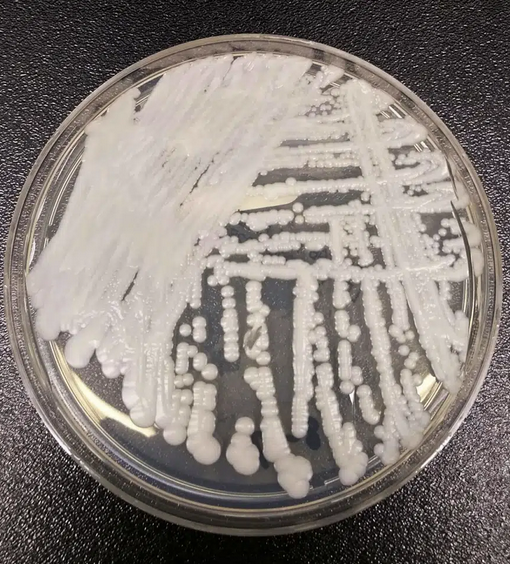
點擊查看大圖

“緊急威脅!”致命病菌在美感染激增,近半數病患90天內死亡
刘程辉风物长宜放眼量
(觀察者網訊)當地時間3月20日,美國疾病控制與預防中心(CDC)在一項最新研究中警告稱,耳念珠菌正以“驚人的速度”在美國傳播開來,截至去年12月已蔓延全美一半以上的州,成為緊急公共衞生威脅。這種病菌具有強耐藥性和較高的致死率,CDC數據表明,近半數感染耳念珠菌的病患會在90天內死亡。


CNN、《財富》雜誌報道
綜合美國有線電視新聞網(CNN)和《財富》雜誌報道,CDC研究人員在美國知名醫學期刊《內科醫學年鑑》發表這項研究,分析了耳念珠菌近年來在美國的傳播和感染狀況。
研究報告指出,耳念珠菌是公共衞生領域面臨的“緊急威脅”,它不僅具有多重耐藥性,很容易通過醫療機構傳播,還可能導致致命疾病。自美國報告發現首例耳念珠菌感染病例以來,被確診感染者人數以及通過篩查發現攜帶這種真菌的人數,正在以驚人的速度增加。
CDC在實驗室中培養耳念珠菌
根據CDC監測數據,感染病例從2016年的53例增至2018年的330例;從2019年到2020年,感染病例增加了59%,達到756人;2021年感染病例激增95%,達到1471人;2022年感染人數進一步上升,達到2377人。
研究還發現,與2019年相比,2020年未確診感染但攜帶這種真菌的人數增加了21%,2021年增加了209%,2021年被檢測出的攜帶者為4041人,而2020年為1310人。
除感染人數不斷膨脹,耳念珠菌遍及的地域也越來越廣。從2019年到2021年,美國有17個州發現了感染病例;截至去年12月,全美已有超過一半的州檢測到耳念珠菌感染病例,其中內華達州、加利福尼亞州和佛羅里達州報告的感染人數最多。

CDC報告顯示,截至2022年12月31日,耳念珠菌已蔓延到美國超過一半的州
CDC稱,耳念珠菌能夠在人類皮膚上生存,從而在人們不經意間傳播開來,長期住院、身患嚴重疾病以及最近服用抗生素或抗真菌藥物的人感染風險更高。雖説它一般不會對健康的人構成威脅,但也正是因為感染通常發生在患有健康問題的重病患者中,這種病菌極易導致“嚴重的高死亡率”。
CDC數據表明,近半數感染耳念珠菌的病患會在90天內死亡。不過CDC專家也表示,尚不清楚有多少死亡病例直接由耳念珠菌導致,因為這些感染者通常也面臨着其他多種健康問題,耳念珠菌可能是直接死亡原因,也可能與其他病因共同加速了死亡。
CDC報告認為,耳念珠菌感染病例增加的原因有很多,特別是在2019年至2021年間,在新冠疫情帶來的巨大壓力下,美國醫療機構很難採取有力措施阻斷病菌傳播。
在治療方面,根據CDC的説法,大多數耳念珠菌感染可以用一類特定的抗真菌藥物治療。然而,耳念珠菌通常具有多重耐藥性,有些菌株甚至對所有三種抗真菌藥物都有耐藥性。CDC數據顯示,90%的感染者對至少一種抗真菌藥物產生耐藥性,而30%的感染者至少對兩種藥物產生耐藥性。
實際上,耳念珠菌並非新近出現的新型菌種。《財富》雜誌指出,耳念珠菌2009年在日本首次被發現,自那以後,巴基斯坦、委內瑞拉、西班牙、以色列、南非和美國等地都報告了由此引發的疫情。
倫敦大學學院醫院傳染病和微生物學顧問、真菌感染專家尼爾·斯通(Neil Stone)表示,耳念珠菌的迅速上升是“一件令人不安的事”,“對某些免疫系統薄弱的患者來説,它(的威脅)可能極其嚴重或危及生命”。
“病例的迅速上升和地理傳播令人擔憂。”這項研究的主要作者、美國CDC流行病學家梅根·萊曼(Meghan Lyman)強調,醫療機構需要繼續監測、增強實驗室能力並提高監測和診斷的速度,以進一步預防和控制感染蔓延。
本文系觀察者網獨家稿件,未經授權,不得轉載。